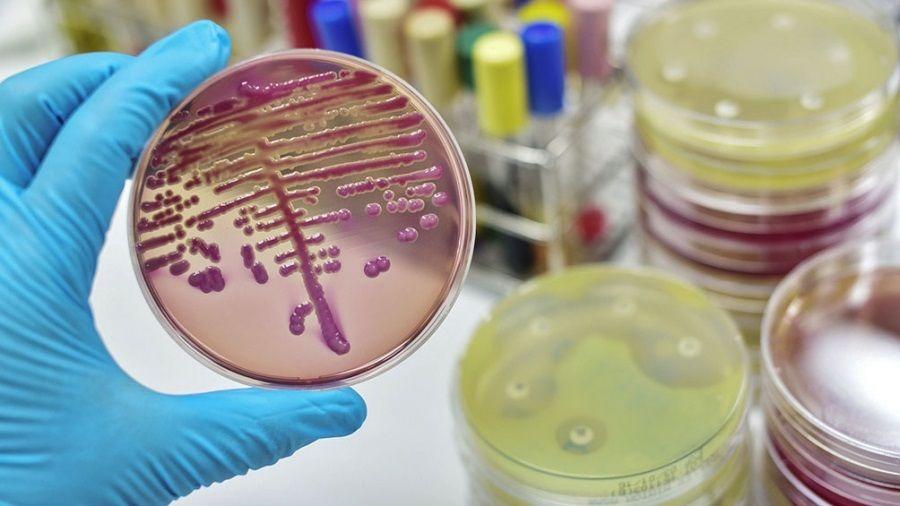
Vizzotti, sobre la resistencia antimicrobiana:

La ministra de Salud, Carla Vizzotti, aseguró que hay que ¨lograr que la sociedad se empodere en que es parte de la solución¨ para combatir la creciente resistencia de bacterias, virus y otros patógenos a los medicamentos, una problemática que alarma a nivel mundial -la OMS estima que para 2050 unas 10 millones de personas morirán por año por esta causa- y se profundizó con la pandemia de coronavirus.
Vizzotti brindó estas declaraciones al encabezar un encuentro multisectorial en el Anlis-Malbrán por la Semana Mundial de Concientización sobre el uso de los Antimicrobianos que comienza el 18/11 y se extiende hasta el 24 de noviembre.
¨La resistencia antimicrobiana (RAM) es un problema de salud pública que ya sabíamos que existía antes de la pandemia y desde el minuto uno supimos que la pandemia lo iba a profundizar¨, sostuvo la ministra.
Y continuó: ¨Ninguna conquista se ha alcanzado si la sociedad no se empodera y nos está costando que la sociedad se empodere con esta problemática. También necesitamos que colegas médicos y medicas accedan a la información¨.
En este sentido, la titular de la cartera sanitaria enfatizó que si bien es una temática en la que hay acuerdo y se viene trabajando desde antes de la pandemia ¨necesitamos hacer algo diferente para que se de un salto, para que se llegue a acciones concretas y para que podamos comunicar de una manera innovadora¨ la magnitud del problema.
La Organización Mundial de la Salud (OMS) estima que para 2050, 10 millones de personas morirán anualmente en el mundo debido a esta causa, una cifra mucho más elevada que otras enfermedades infectocontagiosas (como sarampión y cólera) y crónicas (como diabetes).
¨Argentina y el mundo ya tenían un problema basal, no podemos atribuir todo a la pandemia; lo que hizo la pandemia fue acelerar los tiempos¨, describió durante el encuentro Alejandra Corso, jefa del Servicio de Antimicrobianos del Instituto Nacional de Enfermedades Infecciosas de Anlis Malbrán.
A modo de ejemplo detalló que la resistencia de la bacteria klebsiella pneumoniae (responsable de muchas infecciones oportunistas) pasó en un año del 20% al 30%. ¨Esto no parece mucho, había llevado 10 años que pasara del 10% al 20%¨, sostuvo.
En su comunicado alusivo a la Semana Mundial de Concientización sobre el uso de los Antimicrobianos, la OPS/OMS señaló que ¨son distintos los factores que impulsan la RAM, como el uso inadecuado de antimicrobianos en medicina humana, medicina veterinaria y agricultura¨.
Reunión entre sectores de la salud
El encuentro del jueves 18/11, que dio cuenta de lo multifactorial de la problemática, contó con la participación de la Sociedad Argentina de Infectología (SADI) y la Sociedad Argentina de Terapia Intensiva SATI), organismos de Estado vinculados a la producción agropecuaria (INTA), regulación de medicamentos (Anmat), así como de representantes de los ministerios de Ambiente, Producción y Ciencia y Tecnología, además del sector farmacéutico.
Los expositores coincidieron en el concepto de ¨Una Salud¨ impulsado desde la OMS que contempla la necesidad de comprender que la salud humana, animal y ambiental requieren un abordaje conjunto.
En este marco se lanzó la campaña ¨Antimicrobianos: Manejalos con Cuidado¨, de la Comisión Nacional para el Control de la Resistencia Antimicrobiana (CoNaCra), coordinada por la Dirección Nacional de Epidemiología del Ministerio de Salud, del que participan organismos de distintas carteras (educativa, científica, ambiental, agrícola-ganadera).
El objetivo de esta campaña es ¨poner en conocimiento a nivel masivo la problemática de la resistencia antimicrobiana y sus implicancias para la salud¨, así como ¨promover acciones para la lucha contra la aparición y la propagación de infecciones resistentes a los medicamentos tanto en el público general como en trabajadores de la salud y en decisores públicos con enfoque en ´Una Salud´¨, indicaron.
En el encuentro también se informó que avanza en el Congreso un proyecto de ley sobre la temática que se apoya en cuatro ejes.
¨Darle fuerza de ley a la CoNaCra y al plan nacional de lucha contra la resistencia; la prevención, control y fortalecimiento de los programas de control de consumo de antimicrobianos a nivel de humano y animal y producción agropecuaria; la necesidad de una receta electrónica que conste de diagnóstico para realizar seguimiento para ver si son adecuados o no, y la colocación de un etiquetado frontal que diga que el uso inadecuado sin asesoramiento puede ser perjudicial para la salud¨, explicó Laura Barcelona, coordinadora del Uso Apropiado de Medicamentos, del Ministerio de Salud.
Por su parte, Federico Luna, director de Productos Veterinarios del Senasa, recordó que ¨las bacterias que se vuelven resistentes en los animales pueden llegar a la población a través del consumo directo pero también a través del ambiente¨.
¨Es muy importante lo que hacemos en la salud animal, sin descuidar la producción, pero hay que ser muy prudentes¨, dijo.
Finalmente, desde la SADI y la SATI, coincidieron en que al principio de la pandemia se indicaron numerosos antibióticos que, con el tiempo, se observaron que no eran necesarios, lo cual fue remediado inmediatamente y se ¨frenó¨ esa situación.
La Semana Mundial de Concientización sobre el Uso de los Antimicrobianos, que se celebra cada año del 18 al 24 de noviembre, es una campaña mundial que tiene como objetivo aumentar la concienciación sobre la problemática y fomentar las mejores prácticas entre el público en general, los trabajadores de la salud, los profesionales de la sanidad animal y en salud agrícola, y los responsables políticos para evitar la aparición y propagación de infecciones resistentes a los antimicrobianos.
El lema elegido por la OPS/OMS en esta edición es ¨Corre la voz, frena la resistencia a los antimicrobianos¨.

Por buenapraxis
Por buenapraxis